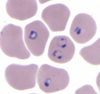

Parasitology Flashcards
(163 cards)
Name the helminth that causes perianal pruritus
Enterobius
What findings on blood smear confirm a diagnosis of malaria?
Trophozoite ring forms within red blood cells and schizonts containing merozoites
A patient has unilateral, nontender periorbital swelling after recent travel to Bolivia. What is the likely diagnosis?
Acute Chagas disease (Romaña sign)
How can Cryptosporidium infection be prevented?
With water filtration
What is the treatment for Loa loa infection?
Diethylcarbamazine
What lab finding might be expected on complete blood count in a patient with hookworm infection?
Microcytic anemia
In what region of the world is Babesia infection most common?
Northeastern United States
What organism causes scabies?
Sarcoptes scabiei
What is the treatment for leishmaniasis?
Amphotericin B, sodium stibogluconate
Which fluke (trematode) is transmitted in undercooked fish?
Clonorchis sinensis
All intestinal nematodes can be treated with which medication?
Bendazoles
What is the specific treatment for a dormant form of malaria?
Primaquine
What 2 methods are used to diagnose an Entomoeba histolytica infection in a blood sample?
Serology and serum antigen testing
How is Naegleria fowleri transmitted?
Acquired from warm freshwater lakes; enters the central nervous system through the cribriform plate
How are diarrhea-causing protozoans transmitted?
Via oocysts/cysts in contaminated water
What is the most appropriate diagnostic test for Naegleria fowleri?
Test for amoebas in the cerebrospinal fluid
Before using chloroquine to treat malaria, what should be verified about the patient’s particular strain of malaria?
Sensitivity to chloroquine; some have developed resistance to this drug
What are the commonly seen symptoms in patients infected withToxocara canis?
Myocarditis, hepatitis, visual impairment/blindness, seizures, and coma (patients also often asymptomatic)
On what continent is Chagas disease predominantly found?
South America
Why should pregnant women avoid cat litter boxes?
Cat feces may contain Toxoplasma oocysts, which can cross the placenta and cause birth defects
What are the common symptoms of Strongyloides stercoralis infection?
Duodenitis, dry cough, hemoptysis, and cutaneous symptoms
Where on the body are Pediculus humanus and Phthirus pubis commonly found?
Scalp/neck (head lice), waistline/axillae (body lice), or pubic/perianal regions (pubic lice)
How do you treat an infection with Strongyloides stercoralis?
Ivermectin or bendazoles
How does the fever pattern differ in malaria caused by Plasmodium vivax, P ovale, P falciparum, and P malariae?
P malariae: every 72 hours (quartan); P vivax/P ovale: every 48 hours (tertian); P falciparum: irregular